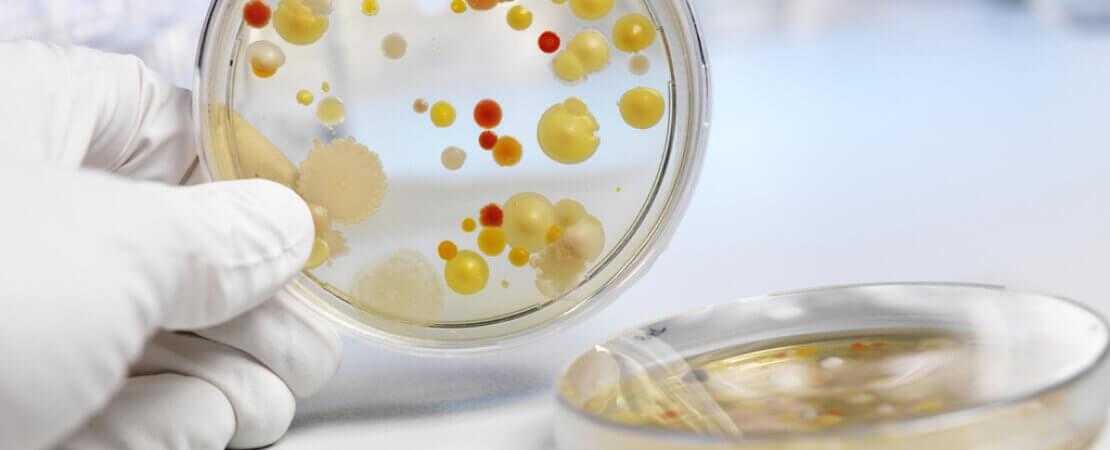

Медикаментозная терапия
Так как болезнь Крона является воспалительным заболеванием кишечника, то нередко ее лечение начинают с противовоспалительных препаратов:
- Глюкокортикостероиды – препараты гормонов коры надпочечников. Они обладают мощным противовоспалительным действием, но эффективны не у всех пациентов с болезнью Крона. Кортикостероиды можно применять кратковременно (в течение 3–4 месяцев) для уменьшения симптомов или для достижения ремиссии. В некоторых случаях их сочетают с иммуносупрессорами – препаратами, подавляющими иммунные реакции. В настоящее время к глюкокортикостероидам обычно прибегают, когда больному не помогают другие методы лечения.
- Пероральные 5-аминосалицилаты широко применялись в прошлом, но в настоящее время показания к их назначению существенно ограничены.
Иммуносупрессоры тоже подавляют воспаление путем угнетения работы иммунной системы. Их нередко применяют в комбинациях, чтобы повысить эффективность лечения:
- Азатиоприн и меркаптопурин – два иммуносупрессора, которые наиболее часто применяют для лечения воспалительных заболеваний кишечника. Во время курса лечения врач должен тщательно наблюдать за состоянием пациента, контролировать показатели крови. Иммуносупрессоры могут настолько ослабить иммунную систему, что повысится риск развития опасных инфекций. Кроме того, они могут привести к воспалению печени. Если начали развиваться эти осложнения – врач должен своевременно их выявить и изменить схему лечения.
- Метотрексат применяется у некоторых пациентов, которым не помогают другие методы лечения. Этот препарат также может вызывать серьезные побочные эффекты и требует контроля состояния пациента, лабораторных показателей во время курса терапии.
Препараты для биологической терапии (биопрепараты) прицельно воздействуют на определенные белки, которые вырабатываются иммунной системой. Это современная группа лекарственных средств, к ней относятся:
- Натализумаб (Тисабри) и ведолизумаб (Энтивио) не позволяют определенным белкам иммунной системы – интегринам – взаимодействовать с клетками слизистой оболочки кишечника. Натализумаб может вызывать очень опасное осложнение – прогрессирующую мультифокальную лейкоэнцефалопатию – поэтому показания к его применению сильно ограничены. Для ведолизумаба таких рисков выявлено не было.
- Инфликсимаб (Ремикейд), адалимумаб (Хумира) и цертолизумаб пегол (Цимзия) входят в группу ингибиторов TNF. Они блокируют белок иммунной системы, который называется фактором некроза опухолей.
- Устекинумаб (Стелара) – наиболее современный препарат, который начал применяться совсем недавно. Он влияет на эффект интерлейкина, белка, принимающего участие в воспалении.
Также при болезни Крона применяют некоторые антибиотики, например, ципрофлоксацин, метронидазол. Считается, что антибактериальные препараты помогают уничтожить болезнетворные микроорганизмы, которые привели к сбою в работе иммунной системы. Кроме того, антибиотики помогают уменьшить отток содержимого свищей и абсцессов, а иногда и полностью их устранить.
Все препараты, описанные выше, относятся к лекарственным средствам, которые помогают контролировать течение болезни Крона. Параллельно проводят симптоматическую терапию. Назначают препараты, которые помогают справиться с проявлениями заболевания:
- Противодиарейные препараты. Такие лекарственные средства, как метамуцил и метилцеллюлоза помогают справиться с легкой и умеренной диареей. При тяжелой диарее помогает лоперамид.
- Анальгетики. В ряде случаев при болезни Крона применяются такие обезболивающие препараты, как ацетаминофен (парацетамол), ибупрофен, напроксен. Однако, в некоторых случаях они могут усугубить течение заболевания и ухудшить симптомы.
- Витамины и минералы. Они могут быть назначены, если из-за нарушения питания в организм пациента не поступают необходимые вещества.
Медикаментозная терапия — последняя надежда
— Какие существуют эффективные методы лечения болезни Крона и язвенного колита?
— Лекарственная терапия при болезни Крона и язвенном колите содержит аминосалицилаты, цитостатики и антицитокиновые препараты, которые блокируют воспалительный очаг заболевания и помогают заживлению слизистой. В итоге так можно остановить рецидивы заболевания.
Недавно в России зарегистрировали новый, но очень эффективный препарат «Ведолизумаб» («Энтивио»). Пока для лечения детей он не предусмотрен, так как препарат ещё не полностью проверен, но ведется исследование по его применению. Но не всё так безнадежно: в Норвегии и Канаде уже был использован этот препарат на детях, и он показал хорошие результаты.
– Знаете ли вы детей, которые нуждаются в этом препарате?
Не всегда медикаменты помогают при заболевании, и приходится прибегать к радикальному лечению– Да. Мы имеем два очень тяжелых пациента. У них обоих ещё до конца не поставили диагноз, и они нуждаются в серьезной терапии. Девочка пережила многое: у нее сначала просто болел живот, спустя некоторое время у нее нашли тяжелое поражение кишечника, опасное для жизни.
Что у мальчика, что у девочки есть поражение ротовой полости и высокой воспалительной активностью в крови. Мы пристально наблюдаем за их состоянием, так как предугадать течение болезни Крона у них невозможно, так как это редкие случаи.
Мы опасаемся того, что заболевание обретет более поражающий характер, сужению кишки. В этом случае незамедлительно потребуется хирургическое вмешательство, дети станут инвалидами, а заболевание может прогрессировать дальше.
Мы советуемся с иностранными клиниками и их опытом, так как думаем о применении препарата «Ведолизумаб», который может спасти детей. Если ничего не получится, будем рассматривать вариант трансплантации костного мозга.
– И к какому решению, как вы думаете, придете?
– Безусловно, первый вариант, а именно принятие нового препарата, является более безопасным вариантом для детей и сохранения их здоровья. Трансплантация костного мозга может иметь серьезные последствия и осложнения.
Государство пока закупает препарат исключительно для взрослых, но есть возможность использования его для детей по особо важным показаниям. Мы уверены, что мы сможем довести детей до ремиссии и минимизировать риск осложнений. Мы очень надеемся, что все получится и в дальнейшем все регионы страны смогут использовать этот препарат.
Видео: «Неспецифический язвенный колит: причины и симптомы»
– Насколько возможна полноценная жизнь у ребенка при таком заболевании и в состоянии ремиссии?
Важная задача у врачей научить ребенка жить с болезнью Крона– Чтобы показать это, у меня есть папка с рисунками больных, где они изображали то, как они видели свою жизнь до терапии специальными препаратами и после неё. Невооруженным глазом заметна разница. На рисунках до проведения терапии преобладал черный и серый цвет, чувствовалась тревога и уныние.
После — уже более позитивная картина, некоторые рисуют солнце, цветы, радугу, некоторые семью, свои цели, мечты, желания.
Именно на сравнение этих картин мимолетно осознаешь, как же меняется жизнь пациентов после терапии. Несомненно, применение новых препаратов — это как глоток спасительного воздуха для пациентов.
Наша основная задача после терапии — адаптировать ребенка к новой жизни, научить его жить с болезнью Крона, язвенным колитом, ведь иногда болезнь может обостриться.
Также мы советуем ребятам в будущем искать работу со свободным графиком, чтобы не иметь проблем с начальством из-за частых больничных.
Можно научиться жить полноценно, даже несмотря на такую страшную болезнь. Нужно соблюдать правильную диету, умеренную нагрузку и позитивный настрой, и именно тогда все получится! Мы желаем всем нашим пациентам безграничного здоровья и терпения в преодолении такой сложной болезни.
Автор статьи: Морозова Людмила Васильевна
Эндоскопист
Проводит эндоскопическую диагностику патологий желудочно-кишечного тракта. Делает заключения на основании результатов осмотра, а также проводит лечебные манипуляции при гастритах, язвах и других нарушениях в ЖКТ.
Комментарии для сайта Cackle
Причины болезни Крона
Нет оснований полагать, что употребление в пищу тех или иных продуктов может вызвать болезнь Крона, но изменение рациона питания может облегчить определенные симптомы. Поэтому врачи и диетологи рекомендуют больным с воспалительными заболеваниями кишечника специальную диету.
Точная причина болезни Крона неизвестна. Большинство исследователей полагают, что ее вызывает комбинация факторов.
Генетическая предрасположенность. Есть доказательства того, что в появлении болезни Крона определенную роль играет генетика. Исследователями было установлено свыше 200 различных генов, которые чаще встречаются у людей с болезнью Крона, чем у остальных. Есть также свидетельства того, что болезнь Крона может передаваться по наследству. Примерно у 3 из 20 людей с болезнью Крона есть близкий родственник (мать, отец, сестра или брат) с таким же заболеванием. А если у вас есть однояйцевый близнец с этим заболеванием, вероятность того, что вы тоже заболеете, составляет 70%.
Тот факт, что у некоторых народностей болезнь Крона распространена более, чем у других, также указывает на важную роль, которую играет генетика.
Иммунная система защищает организм от вредных бактерий, которые могут попасть в пищеварительную систему. В тоже время, в кишечнике живет большое количество различных полезных бактерий, которые участвуют в переваривании пищи. Иммунная система обычно распознает эти бактерии и не трогает их, однако при болезни Крона что-то нарушает ее работу, и организм выделяет особый белок, который называется «фактор некроза опухоли-альфа». Этот белок приводит к уничтожению всех бактерий, полезных и вредных, что вызывает воспаление кишечника, характерное для болезни Крона.
Перенесенное инфекционное заболевание. У некоторых генетически предрасположенных людей перенесенные в детстве инфекционные заболевания могут вызывать расстройство иммунной системы, что приводит к появлению симптомов болезни Крона. Одной из причин таких нарушений считают паратуберкулез — инфекционное заболевание, которое обычно встречается у коров, овец и коз. Возбудитель паратуберкулеза — Mycobacterium avium. Как показывают исследования, у людей с болезнью Крона эта микобактерия обнаруживается при анализе крови в семь раз чаще, чем у остальных людей
Известно, что микобактерия выживает в процессе пастеризации (термической обработки), поэтому ей можно заразиться через молоко больных животных. Вместе с тем, точная роль паратуберкулеза в развитии болезни Крона до конца не изучена, и некоторые исследователи опровергают вышеизложенную теорию.
Курение. Наряду с наследственностью и этническим происхождением, курение является наиболее важным фактором риска при болезни Крона. У курильщиков вероятность появления заболевания в два раза выше. Более того, у курильщиков с болезнью Крона симптомы бывают более выражены, чем у некурящих людей. Прочитайте подробнее о том, как бросить курить.
Факторы внешней среды. Есть два необычных аспекта болезни Крона, из-за которых многие эксперты считают, что факторы внешней среды могут играть роль в развитии заболевания. Они описаны ниже.
- Болезнь Крона — это «болезнь богатых». Больше всего заболеванию подвержены жители развитых стран мира, например, США и Великобритании, а меньше всего — жители развивающихся стран Азии и Африки.
- Болезнь Крона стала распространяться с 1950-х годов. Это говорит о том, что-то в образе жизни современных жителей стран Запада повышает вероятность появления заболевания.
Так, согласно гипотезе гигиены, современные городские дети растут во все более «чистой» среде, не контактируя с бактериями, и их иммунная система остается недоразвитой, так как ребенок не болеет детскими инфекционными заболеваниями, однако убедительных свидетельств этого нет.
Патогенез
Болезнь Крона развивается, когда под влиянием всевозможных факторов (наследственной предрасположенности и генетических мутаций, активности микроорганизмов и нарушений в работе иммуннитета) происходит активация воспалительного ответа со стороны иммунной системы. Действие иммунной системы приводит к повреждению стенки кишки. При этом, отличительной чертой болезни является возникновение язв, затрагивающих всю толщину стенки кишки.
Со временем слизистая кишечника принимает характерный вид «булыжной мостовой» — участки язв и трещин чередуются с участками скопления иммунных клеток и отека слизистой оболочки (рис. 2).

Болезнь Крона у взрослых
Болезнь Крона считается болезнью молодых — заболевают, преимущественно, люди среднего возраста, пик заболеваемости приходится на 15-35 лет. Среди старшей возрастной группы отмечается второй пик — после 60 лет.
При этом заболевание имеет распространенный характер поражений — в отличие от других болезней из группы ВЗК («воспалительные заболевания кишечника») она может затрагивать любые отделы пищеварительного тракта, начиная от ротовой полости, заканчивая прямой кишкой (рис.3).
Болезнь Крона, как и многие другие из группы аутоиммунных заболеваний, имеет хроническое течение — так или иначе, возникнув однажды, она будет сопровождать больного в течение многих лет. Однако при условии грамотно подобранного лечения симптомы заболевания часто можно свести к минимуму.
Болезнь Крона у детей
Дебют болезни Крона у детей случается в среднем в 10-15 лет. При этом чаще болеют мальчики. Так же, как и у взрослых, у детей могут поражаться любые отделы пищеварительного тракта, однако наиболее часто заболевание протекает в форме илеоколита, колита и илеита.
Симптомы болезни Крона
Общие проявления
При такой патологии как болезнь крона, симптомы в основном неспецифичны.
Это прежде всего:
- снижение температуры тела;
- продолжительная диарея с болями в животе;
- потеря веса;
- общая утомляемость.
Может развиться спазматическая или устойчивая боль в правом нижнем квадранте. Боль предшествует дефекацией и может быть частично ослаблена ею. Диарея обычно не сильно кровянистая и часто прерывистая. Если вовлечена ободочная кишка, пациенты могут сообщать о диффузной боли в животе, сопровождающейся слизью, кровью и гноем в стуле.
Важно отметить, что болезнь Крона с локализацией в толстой кишке может быть клинически неотличима от язвенного колита, с симптомами кровавой слизисто-гнойной диареи, спазмами в животе и срочностью дефекации. Болезнь Крона с локализацией в тонкой кишке обычно имеет признаки мальабсорбции, включая диарею, боль в животе, потерю веса и анорексию. Первоначально эти симптомы могут быть стертыми.
Болезнь Крона с локализацией в тонкой кишке обычно имеет признаки мальабсорбции, включая диарею, боль в животе, потерю веса и анорексию. Первоначально эти симптомы могут быть стертыми.
У пациентов с поражением гастродуоденальной области чаще возникают анорексия, тошнота и рвота. Те, у кого есть перианальное заболевание, могут иметь изнурительную боль в области прямой кишки, неприятные выделения из свища и обезображивающие шрамы от активного заболевания или предыдущей операции.
Пациенты также могут предъявлять жалобы на кишечную непроходимость. Первоначально обструкция вторична по отношению к воспалительным отекам и спазмам кишечника и проявляется в виде вздутия живота после еды и спазматических болей (нижний правый квадрант). Как только просвет кишечника становится хронически суженным от фиброза, пациенты могут жаловаться на запоры. Эти симптомы обычно не улучшаются с противовоспалительными средствами. Полная обструкция иногда может быть вызвана воздействием непереваренных продуктов.
Болезнь Крона у взрослых в 45% случаев протекает с поражениями в подвздошной и ободочной кишке, 20% только в толстой кишке, 33% в тонкой кишке и 5% в гастродуоденальной области и только перианальной области (свищ, абсцесс, анальная язва или стриктура, или трещина). Почти 20-23% пациентов с заболеваниями толстой или тонкой кишки имеют перианальные осложнения, которые могут предшествовать развитию кишечных симптомов и проявляться в виде простых меток кожи, анальных трещин, перианальных свищей или абсцессов.
Болезнь крона у детей вызывает воспаление желудка, двенадцатиперстной кишки или то и другое в 30-40% случаев. Основным проявлением поражения поджелудочной железы становится панкреатит. Терминальная подвздошная кишка поражена у 50-70% детей. Более половины этих пациентов также имеют воспаление в различных сегментах толстой кишки, обычно в восходящей толстой кишке.
Внекишечная вовлеченность
Внекишечные проявления могут возникать в самых разных органах и частях тела, включая рот, задний проход, глаза, кожу, суставы, печень и желчные протоки.
Афтоидные язвы и эрозии рта, анальные трещины, абсцессы, изъязвления вокруг стом и кожных пятен присутствуют почти всегда. Часто встречаются увеит и эписклерит, а также гангренозная пиодермия и конституциональная экзема.
Артропатии — еще одно из типичных внекишечных проявлений болезни Крона. Они имеют тенденцию быть мигрирующими и асимметричными. Также возможен связанный с болезнью анкилозирующий спондилит.
Распространены и нарушения функции печени, но тяжелая патология печени, такая как перихолангит и первичный склерозирующий холангит, не так отчетливо ассоциируется с болезнью Крона, как с язвенным колитом.
Дисплазия и рак
Пациенты с колитом Крона подвергаются повышенному риску развития интраэпителиальной неоплазии, также известной как дисплазия и аденокарцинома толстой кишки. Считается, что пациенты с сопутствующим первичным склерозирующим холангитом имеют повышенный риск развития колоректальной неоплазии по сравнению с другими пациентами Крона.
Общие сведения о заболевании
Болезнь Крона относится к хроническим воспалительным заболеваниям, протекающим с обострениями и ремиссиями. Симптомы патологии разнообразны и не всегда ярко выражены. К ним относится диарея, тошнота, спазмы в животе, субфебрильная температура, изменение характера аппетита, снижение веса, утомляемость. Ухудшается цвет кожи, появляются плохо заживающие гнойнички и язвочки. Врачебная практика показывает, что у многих пациентов симптоматика слабо выражена или практически отсутствует.
Признаки болезни Крона схожи с проявлениями неспецифического язвенного колита, сложного аутоиммунного заболевания. Разница состоит в локализации очагов поражения. При болезни Крона нарушаются функции всех отделов ЖКТ, при НЯК поражается толстая кишка. В первом случае воспалительный процесс распространяется на стенки кишечника по всей толщине, при неспецифическом язвенном колите воспаляется слизистая оболочка толстой кишки. Для болезни Крона характерным является чередования здоровых и воспаленных сегментов кишечника, в то время как при колите очаг поражения не прерывается и захватывает определенный участок. Примерно в 10% случаев у врачей возникают затруднения при проведении дифференциальной диагностики (так называемый неопределенный колит), но со временем патология приобретает выраженные черты конкретного заболевания.
Болезнь Крона относится к заболеваниям с неопределенным характером течения. Это значит, что у одних людей симптомы могут не проявляться годами, а у других обострения регулярно повторяются. Тем не менее, болезнь считается хронической, независимо от характера проявления. Это означает, что на сегодняшний день не существует методик для кардинального излечения от патологии.
Усилия медицинских специалистов направлены на улучшение качества жизни людей, установление контроля над ходом течения, предотвращение обострений и осложнений болезни. Большинство пациентов, наблюдающихся у гастроэнтеролога, ведут полноценную жизнь, сохраняют трудоспособность и социальную активность.
Диетические рекомендации
Универсальной диеты, которая могла бы улучшить состояние всех пациентов с болезнью Крона, не существует. В первую очередь, больной должен разобраться, какие продукты вызывают у него ухудшение, и постараться исключить их из рациона. Задача диеты при болезни Крона – разгрузить кишечник, дать ему «отдохнуть», чтобы он мог восстановиться.
Продукты, которые чаще всего приводят к усугублению течения заболевания: алкоголь в любом виде, масло, майонез, маргарин, газированные напитки, кофе, чай, шоколад, кукуруза, молочные продукты (если пациент страдает непереносимостью лактозы), жирная, жареная пища, продукты с высоким содержанием клетчатки, чечевица, фасоль, бобовые, капуста, брокколи, лук, орехи и семечки, сырые фрукты и овощи, красное мясо, острое, цельнозерновые продукты, отруби.
Пациенту рекомендуют вести пищевой дневник, записывать в него всё, что он ел, делать отметки о своем самочувствии. Это помогает выявить все нежелательные продукты и подобрать оптимальный рацион. От некоторых видов пищи не обязательно отказываться вовсе. Например, если симптомы усиливают сырые овощи, можно попробовать употреблять их в вареном виде. Если проблемы вызывает мясо, то можно попробовать перейти на фарш. Составление диеты – это определенная работа, которая занимает некоторое время, и ее должен выполнять пациент вместе с лечащим врачом и диетологом.
Многим пациентам, особенно тем, у кого имеются симптомы нарушения проходимости кишечника, рекомендуется исключить продукты, богатые клетчаткой. Это нужно, чтобы уменьшить объем стула и не допустить развития кишечной непроходимости.
Другие статьи
Амирсеидов Низами Магомедович
андролог, уролог
Уреаплазмоз: нужно ли лечить?
Уреаплазмоз — это группа воспалительных и дисбиотических заболеваний, поражающих мочеполовую систему.
23 марта 2023
Шамиева Самра Асимовна
гинеколог, гинеколог-эндокринолог, кольпоскопист, узи гинекологии

Что такое эндометриоз у женщин?
Эндометриоз — это заболевание с хроническим течением, при котором за пределами матки обнаруживаются ткани, подобные эндометрию.
20 марта 2023
Петухова Ольга Викторовна
гастроэнтеролог

Что такое туберкулёз и как его диагностировать?
Туберкулез — это инфекционное заболевание. Оно вызывается попаданием в организм микобактерии туберкулеза (Mycobacterium tu…
17 марта 2023
Алиев Исмаил Абдуллаевич
обрезание, ортопед, сосудистый хирург, травматолог, хирург

Если у вас родинка на теле?
Родинки, кератомы, невусы, папилломы, бородавки, кондиломы и др. – всё это относится к кожным образованиям.
15 марта 2023
Болезнь Крона: причины, симптомы
В настоящее время достоверная причина этого хронического воспалительного заболевания кишечника неизвестна. Ученые смогли выделить лишь предрасполагающие факторы, которые способны увеличить риск развития данной патологии. Механизм появления болезни в настоящее время объясняется несколькими гипотезами, которые нуждаются в дополнительном научном подтверждении:
Генетическая предрасположенность Медики описывают около 160 генов, изменения в которых могут стать причиной развития заболевания. Некоторые из них способны повышать риск развития заболевания в 20-40 раз.
Факторы окружающей среды Достоверно известно, что риски развития болезни Крона увеличены в социально развитых странах, особенно — в северных регионах.
Инфекционная нагрузка Нарушение барьера слизистой оболочки и сбой в деятельности клеток тонкого кишечника приводит к снижению местного иммунного ответа. В результате повышается выживаемость бактерий, которые начинают активно размножаться. Системный иммунный ответ приводит к развитию хронического воспаления в различных отделах желудочно-кишечного тракта.
Несмотря на то что гипотезы не дают достоверной информации о происхождении заболевания, они объясняют его многофакторность. Заболевание неясной этиологии, характеризующееся многообразием симптомов, нуждается в дополнительном изучении проблемы.
Факторами, предрасполагающих к появлению болезни Крона являются:
- Возраст Наиболее часто пик заболеваемости приходится на возраст 15-35 лет. В некоторых странах — 20-40 лет.
- Отягощенная наследственность Близкий родственник с болезнью Крона увеличивает риск развития заболевания. Около 25% пациентов имеют родственников с аналогичным диагнозом.
- Расовая принадлежность Наиболее подвержены болезни Крона лица европеоидной расы.
- Курение Эта вредная привычка не только способствует появлению болезни, но и ее прогрессированию. У курильщиков значительно ухудшается прогноз.
- Аппендэктомия (удаление аппендицита) В настоящее время механизмы этого явления слабо изучены. Однако, есть мнение о том, что это связано с иммунной функцией червеобразного отростка.
Диагностика
Критерии по Lennard-Jones: при наличии хотя бы трех любых признаков из списка вероятность болезни Крона высока:
- Поражение от полости рта до анального канала: хроническое гранулематозное поражение слизистой оболочки губ или щек; пилородуоденальное поражение, поражение тонкой кишки, хроническое перианальное поражение;
- Прерывистый характер поражения;
- Трансмуральный характер поражения: язвы-трещины, абсцессы, свищи;
- Фиброз: стриктуры;
- Лимфоидная ткань (гистология): афтоидные язвы или трансмуральные лимфоидные скопления;
- Муцин (гистология): нормальное содержание муцина в зоне активного воспаления слизистой оболочки толстой кишки;
- Наличие саркоидной гранулемы (при подтверждении гранулемы достаточно наличие всего одного признака из списка).
Инструментальные методы
Диагностика болезни Крона основана на данных рентгенологического и эндоскопического исследования с биопсией, которые выявляют воспалительное поражение одного или нескольких участков желудочно-кишечного тракта, обычно распространяющееся на все слои кишечной стенки.
Минздрав РФ рекомендует следующие методы инструментального обследования:
- обзорная рентгенография брюшной полости (при симптомах кишечной непроходимости)
- колоноскопия с илеоскопией
- эзофагогастродуоденоскопия
- МРТ, КТ с контрастированием кишечника (диагностика свищей, абсцессов, инфильтратов);
- фистулография (при наличии наружных свищей);
- при невозможности провести МРТ или КТ допустимо рентгеноконтрастное исследование тонкой кишки с бариевой взвесью (после исключения признаков непроходимости)
- биопсия слизистой оболочки кишки в зоне поражения
- ультразвуковое исследование органов брюшной полости, забрюшинного пространства, малого таза
- трансректальное ультразвуковое или МР-исследование прямой кишки и анального канала (при перианальных поражениях).
Европейское медицинское сообщество считает рентгенографию весьма ограниченным методом в диагностике болезни Крона и отдает предпочтение компьютерной томографии.
Эндоскопия верхних или нижних отделов желудочно-кишечного тракта (при необходимости — с биопсией) позволяет подтвердить диагноз и уточнить локализацию поражения.
При колоноскопии у больных, перенесших операцию, можно оценить состояние анастомозов, вероятность рецидива и эффект лечения, проводимого после операции.
Биопсия может подтвердить диагноз болезни Крона, в частности отличить ее от неспецифического язвенного колита, выявить дисплазию или рак.
О воспалении кишечной стенки свидетельствуют лейкоциты в кале. При поносе (в начале заболевания или при рецидиве) кал исследуют на возбудителей кишечных инфекций, простейших, яйца гельминтов и клостридий.
Какое обследование необходимо при подозрении на болезнь Крона?
Заболевание помогают выявить следующие исследования и анализы:
- Эндоскопические методики: ректороманоскопия (осмотр прямой и сигмовидной кишки), колоноскопия (осмотр ободочной кишки). Врач вводит через задний проход пациента специальное эндоскопическое оборудование с видеокамерой и проводит осмотр слизистой оболочки кишки. Эти исследования отличаются высокой информативностью, при этом они не требуют общего наркоза, не нужно делать разрез, на организм во время процедуры не действуют никакие излучения. Колоноскопию широко применяют для скрининга и ранней диагностики различных заболеваний кишечника, в том числе злокачественных новообразований.
- Рентгеноконтрастные исследования кишечника. При подозрении на поражение толстого кишечника проводят ирригографию. Пациенту вводят при помощи клизмы рентгеноконтрастный раствор, а затем делают рентгеновские снимки — на них хорошо видны контуры заполненной контрастом кишки.
- Биопсия. Во время эндоскопических исследований врач может взять фрагмент «подозрительного» участка слизистой оболочки кишечника при помощи специальных инструментов и отправить его в лабораторию.
- Общий анализ крови. Выявляется анемия, воспалительные изменения.
- Биохимический анализ крови позволяет выявить снижение содержания белков, жиров, глюкозы, кальция.
- Анализы кала: микроскопия, бактериологическое, химическое исследование.
- Компьютерная томография (КТ) и позитронно-эмиссионная томография (ПЭТ).
Лечение болезни Крона у детей: клинические рекомендации
Главная цель лечения – это достижение и удержание ремиссии. Для этого преимущественно используют консервативную терапию, которая предусматривает:
При особо тяжелом клиническом течении, а также если консервативное лечение не приносит эффекта, назначается хирургическое вмешательство. В ходе щадящей операции пораженный участок кишечника удаляют, а концы здорового – соединяют между собой. Это помогает избавиться от очага патологии, а также убрать абсцессы и гнойниики
Важно учитывать, что удаление фрагмента кишечника не помогает избавиться от болезни: воспаление неизбежно разовьется в другом отделе. Однако это позволяет убрать опасные очаги и удержать ремиссию
Профилактика и прогноз при болезни Крона
Способов полного излечения от этого заболевания на сегодняшний день не разработано вследствие того, что этиология и патогенез заболевания до конца не ясны. Однако, регулярная адекватная терапия обострений и соблюдения диеты и режима, врачебных рекомендаций и регулярное санаторно-курортное лечение способствуют снижению частоты обострений, уменьшению их тяжести и повышению качества жизни.
Основные, ключевые моменты профилактики обострений:
- диетотерапия, сбалансированность питания, применение витаминных комплексов, необходимых микроэлементов;
- избегание стрессов, развитие стрессоустойчивости, регулярный отдых, здоровый режим жизни, нормализация биоритмов;
- физическая активность (легкие физические нагрузки снижают влияние стрессов, нормализуют кишечную деятельность);
- отказ от курения и злоупотребления алкоголем.
У 13-20% больных отмечается хроническое течение заболевания. При правильно проводимом лечении длительность периодов ремиссии достигает нескольких десятков лет. Как самостоятельное заболевание, болезнь Крона очень редко является причиной смерти больных, и процент летальности остается крайне низким. Обычно пациенты, получающие поддерживающую терапию, доживают до глубокой старости.
Методы диагностики
Чтобы обнаружить патологические изменения в кишечнике при болезни Крона, применяют следующие методы диагностики:
- Колоноскопия – эндоскопическое исследование толстой кишки с помощью специального инструмента в виде тонкого гибкого шланга, колоноскопа. Во время этой процедуры врач-эндоскопист осматривает слизистую кишки на всем протяжении и, обнаружив патологически измененные ткани, может сразу удалить их образец и отправить на гистологическое исследование в лабораторию (провести биопсию). Обнаружение воспалительных элементов – гранулем – во время изучения ткани под микроскопом помогает подтвердить диагноз болезни Крона.
- Видеокапсульная эндоскопия в некоторых случаях может быть применена как альтернатива колоноскопии. Пациента просят проглотить небольшую капсулу, в которую встроена миниатюрная видеокамера. Она проходит через весь пищеварительный тракт и записывает изображение.
- Компьютерная томография помогает оценить состояние не только кишечника, но и других органов. Зачастую проводят КТ-энтерографию – КТ в сочетании с применением контрастного раствора. Это исследование в настоящее время практически полностью заменило рентгенографию с контрастом, которая широко применялась ранее.
- Магнитно-резонансная томография особенно полезна для оценки свищей.
- Баллонно-ассистированная энтероскопия – эндоскопическое исследование тонкой кишки с помощью специального эндоскопа и трубки с раздуваемым баллоном. Во время этой процедуры, так же, как и во время колоноскопии, можно провести биопсию.
Лабораторные исследования при болезни Крона включают общий анализ крови, тесты на инфекции, копрограмму, анализ стула на скрытую кровь, на наличие паразитарных инфекций.






























